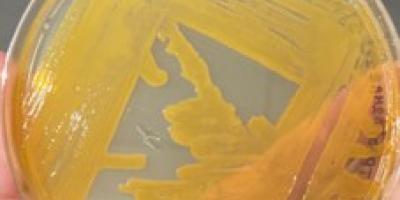
Análisis metagenómica, asignación taxonómica

En el sur del Ecuador se encuentra el 73% de cabras del país, criadas extensivamente dando lugar a que estén expuestas a peligros como es el ataque de depredadores principalmente el...
0
Proyectos de Investigación
En ejecución
En ejecución
FIG. | Aislado puro de muestras colectadas en la Reserva Madrigal
Esta investigación tiene como objetivo explorar la diversidad y composición...
Finalizado
FIG. | Chlorella sp, lente de visualización 40X.
...
En ejecución
Fig. | Línea de tiempo (0, 24 96, 120 horas después de inoculación) de la progresión de cambio citopáticos en Acanthamoeba castellanii ATTCC 30010 provocada por la posible presencia de virus gigantes
...Finalizado
FIG. | Lugares de muestreo, distribuidos entre las provincias de Loja (gris claro) y Zamora Chinchipe (gris oscuro)
La COVID 19 es una infección...